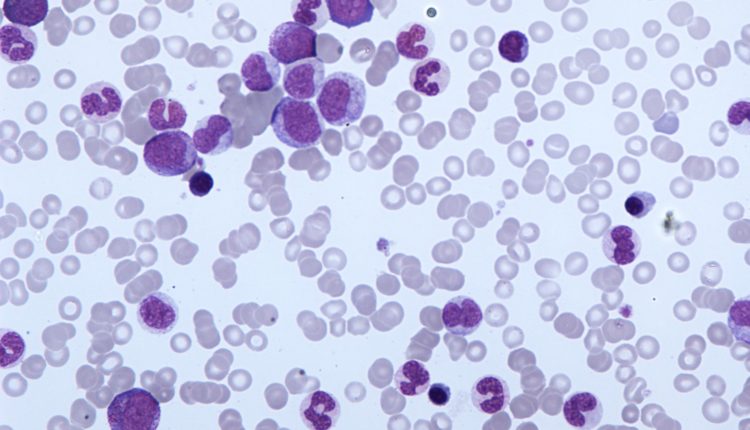
Che Tipo Di Tessuto è Il Sangue Cos'è la leucemia mielomonocitica cronica (CMML)?

Che Tipo Di Tessuto è Il Sangue

Il sangue, spesso associato a ferite e vitalità, è molto più di un semplice liquido rosso. È un tessuto connettivo altamente specializzato, essenziale per la vita, che svolge una miriade di funzioni cruciali nel corpo umano.
Che Cos'è Esattamente il Tessuto Connettivo?
Per comprendere appieno la natura del sangue, è fondamentale capire cosa si intende per "tessuto connettivo". I tessuti connettivi nel corpo includono strutture come ossa, cartilagine, tendini, legamenti e, naturalmente, il sangue. La loro funzione principale è quella di sostenere, connettere e separare diversi tipi di tessuti e organi nel corpo.
A differenza di altri tessuti, i tessuti connettivi sono caratterizzati da una matrice extracellulare abbondante, una sostanza non cellulare che circonda le cellule. Questa matrice è composta da fibre proteiche (come collagene ed elastina) e una sostanza di base, che può essere solida, liquida o gelatinosa. Nel caso del sangue, la matrice extracellulare è il plasma.
I Componenti Principali del Sangue
Il sangue è composto da due componenti principali:
- Plasma: La matrice extracellulare liquida, che costituisce circa il 55% del volume totale del sangue.
- Elementi Figurati: Le cellule del sangue, che comprendono circa il 45% del volume totale del sangue. Questi elementi figurati sono suddivisi in tre tipi principali:
- Globuli Rossi (Eritrociti): Trasportano l'ossigeno.
- Globuli Bianchi (Leucociti): Difendono il corpo dalle infezioni.
- Piastrine (Trombociti): Coinvolte nella coagulazione del sangue.
Il Plasma: La Matrice Liquida
Il plasma è un liquido giallastro composto principalmente da acqua (circa il 92%), proteine (circa il 7%), e piccole quantità di altri soluti come elettroliti, nutrienti, ormoni, gas disciolti e prodotti di scarto. Le proteine plasmatiche più importanti includono:
- Albumina: Mantiene la pressione osmotica del sangue e trasporta alcune sostanze.
- Globuline: Partecipano al sistema immunitario e al trasporto di lipidi.
- Fibrinogeno: Essenziale per la coagulazione del sangue.
Il plasma svolge un ruolo cruciale nel trasporto di nutrienti, ormoni e prodotti di scarto, contribuendo all'omeostasi del corpo. Ad esempio, il glucosio, gli amminoacidi e gli acidi grassi vengono trasportati nel plasma per fornire energia e materiali da costruzione alle cellule di tutto il corpo.
Gli Eritrociti: Trasportatori di Ossigeno
I globuli rossi, o eritrociti, sono le cellule più abbondanti nel sangue. La loro funzione primaria è quella di trasportare l'ossigeno dai polmoni ai tessuti del corpo e l'anidride carbonica dai tessuti ai polmoni. La loro forma a disco biconcavo aumenta la superficie per lo scambio di gas.
Gli eritrociti contengono una proteina chiamata emoglobina, che lega l'ossigeno. L'emoglobina contiene ferro, che conferisce al sangue il suo caratteristico colore rosso. La carenza di ferro può portare all'anemia, una condizione in cui il corpo non ha abbastanza globuli rossi o emoglobina per trasportare l'ossigeno in modo efficiente.
Esempio Reale: Anemia da Carenza di Ferro
Un esempio reale è l'anemia da carenza di ferro. Le donne in età fertile sono particolarmente a rischio di sviluppare questa condizione a causa della perdita di sangue durante il ciclo mestruale. I sintomi includono affaticamento, debolezza, pallore e mancanza di respiro. Un esame del sangue rivelerà bassi livelli di emoglobina e ferritina (una proteina che immagazzina il ferro) nel siero.
I Leucociti: Difensori dell'Organismo
I globuli bianchi, o leucociti, sono parte integrante del sistema immunitario del corpo. Proteggono l'organismo dalle infezioni, dai corpi estranei e dalle cellule tumorali. Esistono diversi tipi di leucociti, ognuno con una funzione specifica:
- Neutrofili: Fagocitano batteri e funghi.
- Linfociti: Comprendono le cellule T, le cellule B e le cellule NK, che svolgono ruoli diversi nella risposta immunitaria.
- Monociti: Si trasformano in macrofagi, che fagocitano detriti cellulari e agenti patogeni.
- Eosinofili: Combattono i parassiti e partecipano alle reazioni allergiche.
- Basofili: Rilasciano istamina e altre sostanze chimiche coinvolte nelle reazioni infiammatorie.
Un aumento del numero di leucociti nel sangue (leucocitosi) può indicare un'infezione, un'infiammazione o un tumore del sangue. Una diminuzione del numero di leucociti (leucopenia) può aumentare il rischio di infezioni.
Esempio Reale: La Leucemia
La leucemia è un tipo di cancro del sangue che colpisce i leucociti. Nella leucemia, le cellule del sangue anormali si moltiplicano in modo incontrollato, sopprimendo la produzione di cellule del sangue sane. I sintomi possono includere affaticamento, infezioni frequenti, sanguinamento e lividi facili. Il trattamento per la leucemia varia a seconda del tipo e dello stadio della malattia, ma può includere chemioterapia, radioterapia e trapianto di midollo osseo.
Le Piastrine: Coagulazione del Sangue
Le piastrine, o trombociti, sono piccoli frammenti cellulari che svolgono un ruolo cruciale nella coagulazione del sangue. Quando un vaso sanguigno viene danneggiato, le piastrine si attivano e si aggregano nel sito della lesione, formando un tappo che aiuta a fermare l'emorragia.
Le piastrine rilasciano anche fattori di coagulazione, sostanze chimiche che innescano una cascata di reazioni che portano alla formazione di fibrina, una proteina fibrosa che rinforza il tappo piastrinico. Una carenza di piastrine (trombocitopenia) può aumentare il rischio di sanguinamento eccessivo.
Esempio Reale: La Trombocitopenia
La trombocitopenia è una condizione caratterizzata da un basso numero di piastrine nel sangue. Può essere causata da una varietà di fattori, tra cui infezioni, farmaci, malattie autoimmuni e tumori del sangue. I sintomi possono includere sanguinamento delle gengive, sanguinamento nasale, lividi facili e petecchie (piccole macchie rosse sulla pelle). Il trattamento per la trombocitopenia dipende dalla causa sottostante.
Il Sangue Come Tessuto Connettivo: Un Riepilogo
In sintesi, il sangue è un tessuto connettivo perché:
- Possiede una matrice extracellulare (il plasma).
- Connette diversi tessuti e organi nel corpo attraverso il trasporto di sostanze.
- Supporta la funzione di altri tessuti e organi attraverso la fornitura di ossigeno, nutrienti e la rimozione dei rifiuti.
- Le sue cellule (globuli rossi, globuli bianchi e piastrine) sono sospese in questa matrice.
La composizione e le funzioni del sangue sono strettamente regolate per mantenere l'omeostasi, l'equilibrio interno del corpo. Disfunzioni nel sangue possono portare a una vasta gamma di malattie, che sottolineano l'importanza di questo tessuto vitale.
Conclusioni e Riflessioni
Comprendere la natura del sangue come tessuto connettivo non è solo un esercizio accademico, ma è fondamentale per apprezzare la complessità e la vulnerabilità del nostro organismo. Il sangue, con i suoi componenti specializzati, svolge un ruolo insostituibile nel garantire la nostra salute e il nostro benessere.
Vi invitiamo ad approfondire ulteriormente la conoscenza del corpo umano e dell'importanza del sangue. Considerate la possibilità di donare il sangue, un atto generoso che può salvare vite umane. Informatevi sulle malattie del sangue e sui modi per prevenirle. Solo attraverso una maggiore consapevolezza possiamo contribuire a proteggere la nostra salute e quella degli altri.

.jpg)












